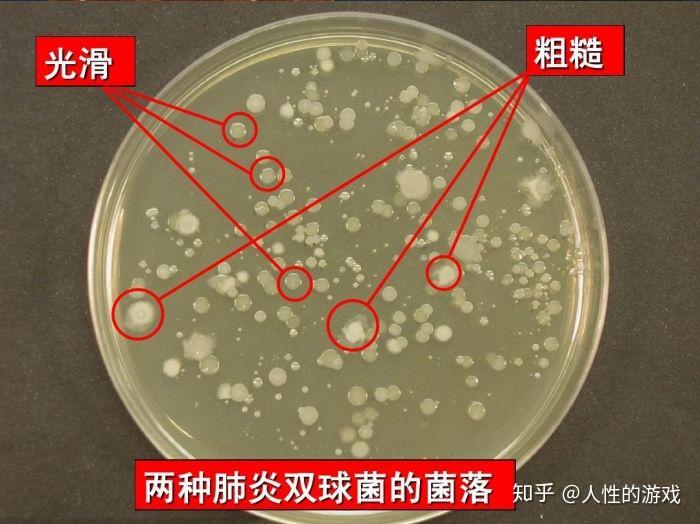
新型冠状病毒46细胞因子s型r型菌落多糖

多糖r

现货供应食品r多糖液体保鲜剂食品添加剂微生物用料原料
图片尺寸800x800
新型冠状病毒46细胞因子s型r型菌落多糖
图片尺寸700x524![晚期会有贫血的情况发生,需要及时补血[种草r]医生推荐服用多糖铁胶囊](https://imgs.wantubizhi.com/img/ADDA3C5D760C6828B77B505A29D43E83B130493912E971524D38715D88CAEFB4D0C970F3FE6D1F03302C47FDFC698C3B28B00FD869BCD7EDB3E47E0A5FF96E2628C397D50E17EC43A2D499C875405926335B0EA2095F60A8FDD91CCFF5E19B38)
晚期会有贫血的情况发生,需要及时补血[种草r]医生推荐服用多糖铁胶囊
图片尺寸1080x1439![我要求下开了钙剂,处方如下:[看r][看r][看r]力斐能 多糖铁复合物胶囊](https://imgs.wantubizhi.com/img/ADDA3C5D760C6828B77B505A29D43E83DEB2419A306D7B9FB43963875B97BC7A08803E89EB7061EF13AA54489B75E954E161F9F236704538FF52CB63F80B3ECC4735C26491855CBF27A5D81EFAD701C4B486FFF123F6101BE1DCD8389439276F)
我要求下开了钙剂,处方如下:[看r][看r][看r]力斐能 多糖铁复合物胶囊
图片尺寸1080x1440
多糖2. 二糖(2)在碱性,加热的的条件下,与新
图片尺寸568x688
干饭人用它来拯救你的小肚子益生菌真绝
图片尺寸1080x1439
我都会喝pacpac左旋肉碱红参咖啡 去水肿里面有左旋肉碱,银耳多糖
图片尺寸1080x1439![[红色心形r]对于高危感染而言,根据我的亲身经历,还是内服免疫补充剂](https://imgs.wantubizhi.com/img/ADDA3C5D760C6828B77B505A29D43E83E7626F80BC8655B550DC80EDF6519797072FB4BA48919AF4092463E1F3520291897A3CEC8FDB30B3002748AC30BF7458103461DEA467889082E5AC2F8F42B1EDA75690F535AFBDF03049085AD2C51D74)
[红色心形r]对于高危感染而言,根据我的亲身经历,还是内服免疫补充剂
图片尺寸1080x1439
现货供应食品添加剂r多糖克霉王液体防腐剂泡菜罐头糕点专用
图片尺寸739x741
光滑(smooth) 有多糖夹膜 s型细菌 有毒性 粗糙(rough) 无多糖荚膜 r
图片尺寸1080x810
iherb晒单naturalfactors生物活性檞皮素山核桃仁灵芝博士茶等
图片尺寸1000x1333
当时查出缺铁性贫血的时候,医生给我开的第一个铁剂,是多糖铁.
图片尺寸1080x1439
河南康美达 直销 r多糖 克霉王 食品级 安全防腐剂 量大从优
图片尺寸750x1259
iherb晒单naturalfactors生物活性檞皮素山核桃仁灵芝博士茶等
图片尺寸1000x1311
mps粘多糖71护肤界扛把子75速来抄作业
图片尺寸1080x1439
被糖黏住的宝宝带你认识黏多糖贮积症
图片尺寸1080x1440
海带多糖价格,采购,货期3日,纯度98%_苏州甫路生物科技有限公司
图片尺寸265x309
类,蛋白质,有机酸,生物碱,甾,十六种氨基酸,甘露醇,灵芝多肽,灵芝多糖
图片尺寸1080x1440![[红色心形r][红色心形r]还好被我发现了这个aime moi粘多糖逆龄丸](https://imgs.wantubizhi.com/img/735A5D1F980B52A636CC46F12F2D1A733BBDC2876AEE5FC83962888DE260CB51C121B4B39A02F7A074CA966D8316B4B7F7133FAF08A9005671E6707FF4DA48ED76380E4123485F9AD3132DD8108B22D9CC71CC3442B9D2060BE5324628853D59)
[红色心形r][红色心形r]还好被我发现了这个aime moi粘多糖逆龄丸
图片尺寸1080x1439
双十一购物指南来啦63省钱攻略必看75
图片尺寸1080x1439

![晚期会有贫血的情况发生,需要及时补血[种草r]医生推荐服用多糖铁胶囊](https://imgs.wantubizhi.com/img/ADDA3C5D760C6828B77B505A29D43E83B130493912E971524D38715D88CAEFB4D0C970F3FE6D1F03302C47FDFC698C3B28B00FD869BCD7EDB3E47E0A5FF96E2628C397D50E17EC43A2D499C875405926335B0EA2095F60A8FDD91CCFF5E19B38)
![我要求下开了钙剂,处方如下:[看r][看r][看r]力斐能 多糖铁复合物胶囊](https://imgs.wantubizhi.com/img/ADDA3C5D760C6828B77B505A29D43E83DEB2419A306D7B9FB43963875B97BC7A08803E89EB7061EF13AA54489B75E954E161F9F236704538FF52CB63F80B3ECC4735C26491855CBF27A5D81EFAD701C4B486FFF123F6101BE1DCD8389439276F)



![[红色心形r]对于高危感染而言,根据我的亲身经历,还是内服免疫补充剂](https://imgs.wantubizhi.com/img/ADDA3C5D760C6828B77B505A29D43E83E7626F80BC8655B550DC80EDF6519797072FB4BA48919AF4092463E1F3520291897A3CEC8FDB30B3002748AC30BF7458103461DEA467889082E5AC2F8F42B1EDA75690F535AFBDF03049085AD2C51D74)










![[红色心形r][红色心形r]还好被我发现了这个aime moi粘多糖逆龄丸](https://imgs.wantubizhi.com/img/735A5D1F980B52A636CC46F12F2D1A733BBDC2876AEE5FC83962888DE260CB51C121B4B39A02F7A074CA966D8316B4B7F7133FAF08A9005671E6707FF4DA48ED76380E4123485F9AD3132DD8108B22D9CC71CC3442B9D2060BE5324628853D59)
